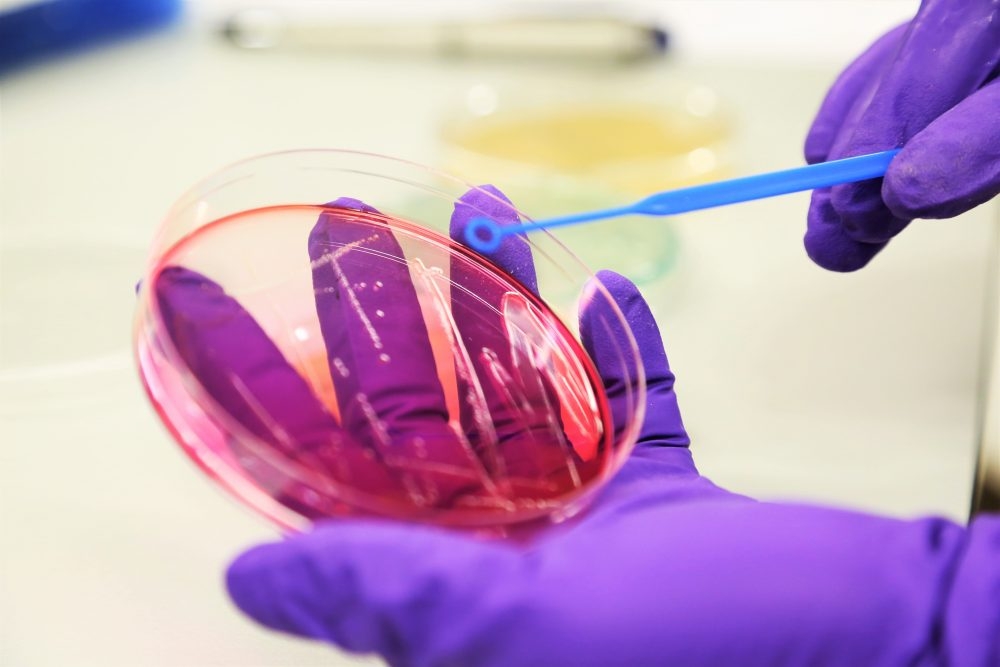

UK Biotech Firm Secures Key Investment To Boost The Fight Against Harmful Bacteria
Pioneering UK biotechnology business, Fixed Phage, has secured additional investment to scale up its fight against new microbial threats that pose risks to human health and agricultural production.
The company, based in Glasgow, has developed an innovative, cost-effective technology that makes bacteriophages – natural antimicrobials – able to eliminate problem bacteria.
The patented solution has wide-ranging potential including treating infections that demonstrate antibiotic resistance, reducing bacterial levels in food, significantly increasing the shelf-life of food, and replacing antibiotics and chemicals currently used in animal feed.
A latest funding round has seen current and new investors, including Scottish Enterprise, pledge a further £2.4 million to support Fixed Phage’s ambitious growth plans, which include upgrading the team’s laboratory facilities at the West of Scotland Science Park, adding a pilot plant to facilitate large scale customer trials and recruiting additional staff to drive collaborative programmes with global partners.
CEO of Fixed Phage, David Browning, says: “The Coronavirus pandemic has highlighted to governments, regulators and industry, the importance of addressing microbial threats.
“We are delighted that current and new investors share the confidence in our team’s ability to impact these challenges with our proprietary technology.”
Jim Reid, Non-executive Director and serial life science investor, added: “Currently there is strong investor interest in companies that are developing tools to combat antimicrobial resistance, and in the UK life sciences sector in general. Fixed Phage is a company developing the right solutions at the right time, leading the development of game-changing technology as the world focuses on the economic, social and health impacts of disease.”
Jan Robertson, interim director of Growth Investments at Scottish Enterprise, said: “Our support for Fixed Phage is characteristic of how we help early-stage Scottish businesses develop their products, secure private investment, scale up their operations and prepare for international growth.
“Having invested in the company shortly after its inception, we’re delighted to provide Fixed Phage with further investment geared towards deepening its talent pool and enhancing its manufacturing capabilities, accelerating the commercialisation of its ground-breaking anti-bacterial technology.
“The life sciences sector makes an increasingly valuable contribution to Scotland’s economy and we hope to see Fixed Phage at the forefront of that for years to come.”
More from Fixed Phage

 5 years ago
5 years ago  1225 views
1225 views
 6 days ago
6 days ago